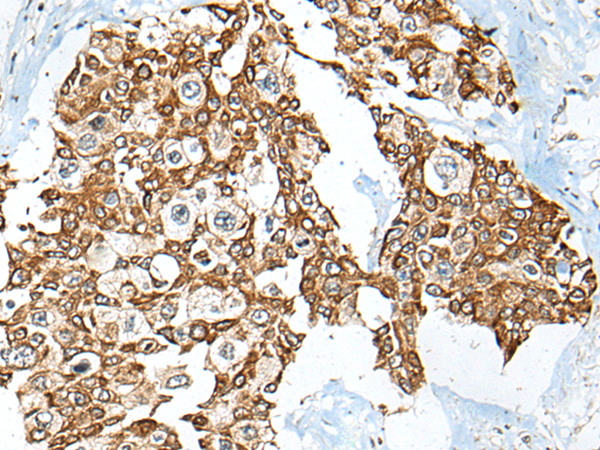

|
Background: |
The ubiquitin (Ub) pathway involves three sequential enzymatic steps that facilitate the conjugation of Ub and Ub-like molecules to specific protein substrates. Through the use of a wide range of enzymes that can add or remove ubiquitin, the Ub pathway controls many intracellular processes such as signal transduction, transcriptional activation and cell cycle progression. USP12 (ubiquitin specific peptidase 12), also known as UBH1 or USP12L1, is a 370 amino acid protein belonging to the peptidase C19 family and the USP12/USP46 subfamily. Considered a deubiquitinating enzyme, it is suggested that USP12 has almost no deubiquitinating activity by itself and requires the interaction with WDR48 to have high activity. The gene encoding USP12 maps to human chromosome 13, which houses over 400 genes, such as BRCA2 and RB1, and comprises nearly 4% of the human genome. |
|
Applications: |
ELISA, IHC |
|
Name of antibody: |
USP12 |
|
Immunogen: |
Full length fusion protein |
|
Full name: |
ubiquitin specific peptidase 12 |
|
Synonyms: |
UBH1; USP12L1 |
|
SwissProt: |
O75317 |
|
ELISA Recommended dilution: |
5000-10000 |
|
IHC positive control: |
Human thyroid cancer and human prostate cancer |
|
IHC Recommend dilution: |
30-150 |

購物車
購物車 幫助
幫助
 021-54845833/15800441009
021-54845833/15800441009
